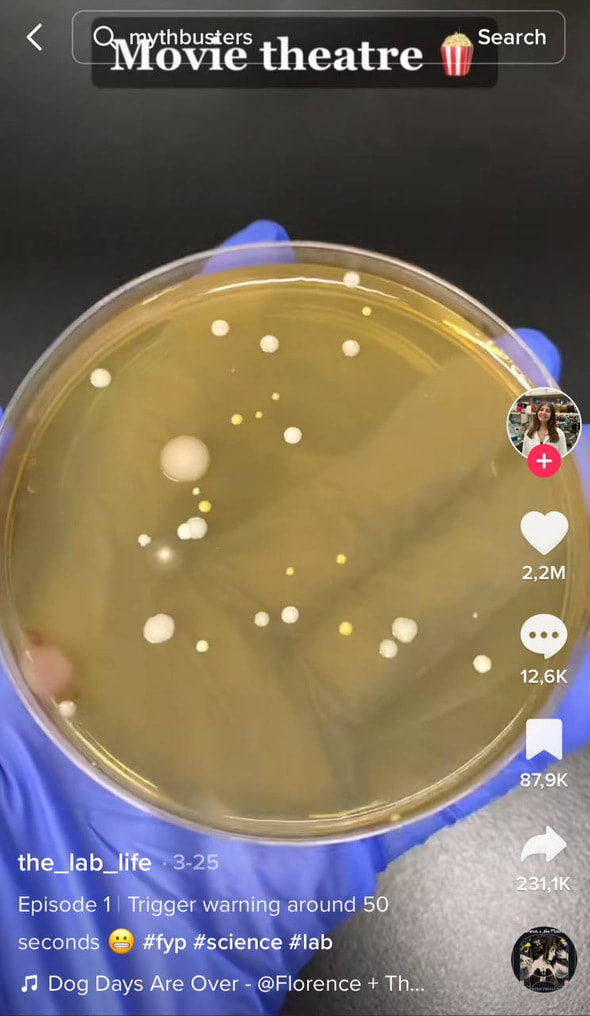

Сушилки для рук оказались не так уж гигиеничны. Новый эксперимент в TikTok
Мы стараемся не трогать двери, ручки и сиденья в общественных туалетах, но этого недостаточно: бактерии попадают на ваши руки, когда вы их сушите после мытья.
Это выяснила студентка медицинского университета, которая ведет в TikTok блог о научных экспериментах. В последнем видео она протестировала чистоту бесконтактных сушилок для рук в туалете торгового центра, кинотеатра и в здании, где она работает.
Она убрала образцы в холодильник, а через несколько дней внутри был замечен грибок, рост которого спровоцировали бактерии (на наших кисточках для макияжа он тоже есть). Ролик набрал более 23 млн просмотров, 2 млн лайков и более 12 тыс. комментариев от пользователей, которых испугал результат.
По словам девушки под ником @the_lab_life, этот эксперимент показывает, что сушилки для рук потенциально могут распространять бактерии, которые приводят к диарее, обезвоживанию и другим инфекциям.
Ученые считают, что бактерии хранятся не в самих сушилках, а витают в воздухе — и из-за мощной струи воздуха из бесконтактных сушилок оседают на руках. Так что если захотите в следующий раз вытереть руки, лучше используйте бумажные полотенца.
Фото обложки: Shutterstock.